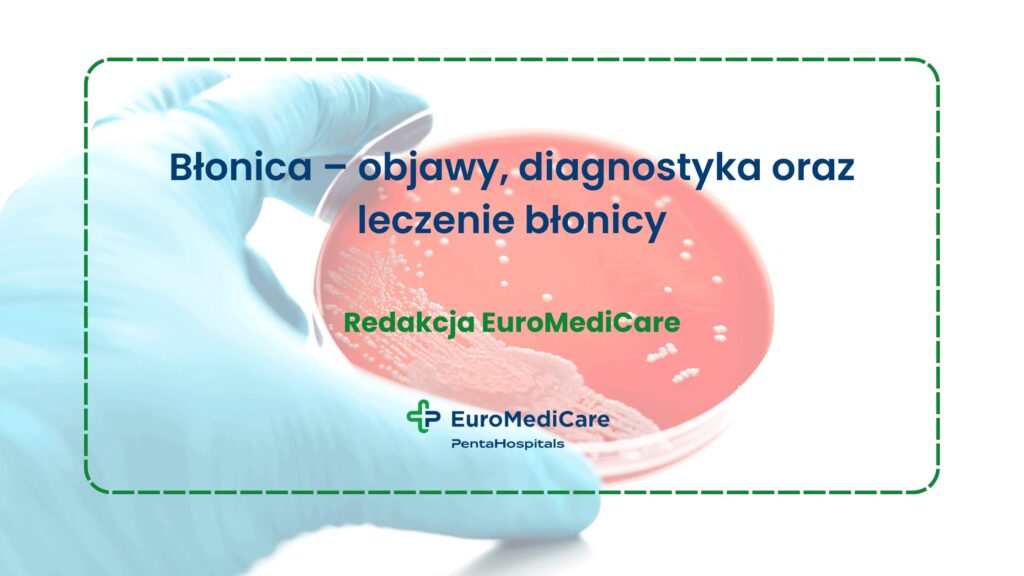
Błonica – objawy, diagnostyka oraz leczenie błonicy

Błonica, znana także jako dyfteryt, krup czy dławiec, to groźna choroba zakaźna wywoływana przez bakterię – maczugowca błonicy (Corynebacterium diphtheriae). Choć w krajach rozwiniętych występuje już bardzo rzadko dzięki powszechnym szczepieniom, to jednak wciąż stanowi poważne zagrożenie dla zdrowia dzieci i dorosłych. Choroba atakuje głównie gardło i drogi oddechowe, powodując trudności w oddychaniu, a w ciężkich przypadkach może prowadzić do niebezpiecznych powikłań neurologicznych oraz sercowych. Sprawdź, jak dochodzi do zakażenia, jakie są objawy błonicy i jak można skutecznie zapobiegać jej rozwojowi.
Z tego artykułu dowiesz się:
- czym jest błonica?
- jak dochodzi do zakażenia błonicą?
- jak objawia się błonica?
- jak wygląda diagnostyka błonicy?
- na czym polega leczenie błonicy?
- czy szczepionka przeciw błonicy jest obowiązkowa?
- jak chronić się przed zakażeniem błonicą?
Co to jest błonica?
Błonica to choroba, która rozwija się w wyniku zakażenia maczugowcem błonicy. Ta Gram-dodatnia bakteria wytwarza toksynę – to właśnie ona powoduje uszkodzenia tkanek i narządów oraz poważne powikłania. Zakażenie obejmuje najczęściej błony śluzowe górnych dróg oddechowych (gardła i krtani), znacznie rzadziej dotyczy innych rejonów (np. błonica nosa, błonica ucha czy narządów płciowych).
W przebiegu choroby na śluzówce tworzą się charakterystyczne szarobiałe naloty błonicze. Mogą one utrudniać choremu oddychanie i połykanie, a w skrajnych przypadkach doprowadzić nawet do uduszenia. Warto jednak wiedzieć, że działanie toksyny nie ogranicza się wyłącznie do gardła czy krtani. Może również spowodować uszkodzenie mięśnia sercowego, układu nerwowego czy nerek. Z tego względu chorobę uznaje się za wyjątkowo niebezpieczną.
Dawniej błonica uchodziła za jedną z najgroźniejszych chorób, szczególnie dla dzieci. Przyczyniała się do wielu epidemii i zgonów, nie tylko wśród najmłodszych. Dopiero wprowadzenie szczepień ochronnych w latach 50. XX w. pozwoliło ograniczyć jej występowanie. Mimo to wciąż istnieje ryzyko jej powrotu, szczególnie w regionach, gdzie jest niski poziom zaszczepienia populacji lub ograniczony dostęp do szczepionek.
Błonica – jak dochodzi do zakażenia?
Do zakażenia dochodzi drogą kropelkową, czyli poprzez kaszel, kichanie lub bliski kontakt z osobą chorą. Należy pamiętać, że nie każdy zakażony Corynebacterium diphtheriae musi wykazywać objawy choroby. Istnieją tzw. nosiciele bezobjawowi – osoby, które same nie chorują, ale mogą przenosić bakterię na innych. To właśnie dlatego błonica rozprzestrzenia się łatwo w społecznościach, gdzie nie ma wysokiego poziomu wyszczepienia. Szczególnie zagrożone są dzieci, seniorzy i osoby z obniżoną odpornością.
Bakterie maczugowca błonicy wnikają przez nos lub usta i atakują organizm, kolonizując śluzówkę dróg oddechowych. Jednak to nie sama bakteria, a produkowana przez nią toksyna jest źródłem uciążliwych dolegliwości. Przedostaje się do krwiobiegu przez zaatakowane tkanki, uszkadzając ważne organy wewnętrzne. Nieleczona błonica krtani prowadzi do niewydolności oddechowej i uduszenia, dlatego bardzo ważne jest, aby pamiętać o wykonaniu szczepień ochronnych we wskazanych okresach.
Jakie są pierwsze objawy błonicy?
Objawy błonicy zależą głównie od jej lokalizacji. W przypadku najczęstszych postaci choroby – błonicy gardła lub krtani – z początku dolegliwości mogą przypominać zwykłe przeziębienie lub infekcję sezonową. Typowym objawem błoniczego zakażenia dróg oddechowych jest pojawienie się na śluzówce tzw. błon rzekomych. To białe lub szarobrązowe błony, które ściśle przylegają do śluzówki. Można je zauważyć podczas oglądania gardła, choć w pierwszej fazie wiele osób myli je z nalotem. Przy jakiejkolwiek próbie ich samodzielnego usunięcia dochodzi do krwawienia.
Pozostałe objawy błonicy gardła to m.in.:
- ból gardła,
- problemy z przełykaniem,
- nieprzyjemny zapach z ust,
- powiększenie węzłów chłonnych, czasem z wyraźnym obrzękiem tkanek miękkich szyi (tzw. szyja bawola),
- osłabienie i uczucie rozbicia,
- gorączka,
- bóle mięśni,
- apatia.
W przypadku błonicy krtani pojawiają się też: chrypka, świszczący oddech i duszność wynikające z utrudnionego przepływu powietrza przez górne drogi oddechowe. W wyniku obrzęku i narastania błon na strunach głosowych może wystąpić szczekający kaszel, a narastająca chrypka przejść w bezgłos.
Błonica – choroba zakaźna i jej powikłania
Błonica nie tylko przyczynia się do powstawania zmian w obrębie gardła i krtani. Działanie toksyny wytwarzanej przez bakterie prowadzi także do zaburzeń funkcjonowania innych narządów oraz układów w organizmie. W zależności od rodzaju, powikłania mogą pojawić się zarówno w ostrej fazie choroby, jak i kilka tygodni po ustąpieniu pierwszych objawów. Do najczęstszych należą:
- niedrożność dróg oddechowych – błony w gardle mogą przyczynić się do uduszenia, a ryzyko zgonu z tego powodu rośnie, jeśli toksyna uszkodzi mięśnie oddechowe,
- zapalenie mięśnia sercowego – toksyna powoduje zaburzenia rytmu serca, niewydolność krążeniową i może prowadzić do nagłego zatrzymania akcji serca,
- powikłania neurologiczne – np. porażenie mięśni oddechowych, porażenie podniebienia miękkiego, porażenie mięśni gałki ocznej, porażenie kończyn,
- wtórne infekcje bakteryjne – np. zapalenie płuc, zapalenie ucha środkowego, zapalenie wsierdzia.
Powikłania błonicy są bardzo niebezpieczne i mogą doprowadzić do zgonu bez odpowiedniego leczenia choroby. Jeśli więc zauważysz, że objawom przeziębienia towarzyszy biały nalot na śluzówce gardła (charakterystyczny dla błonicy dróg oddechowych), jak najszybciej zgłoś się do lekarza.
Jak rozpoznać błonicę?
Jeżeli podejrzewasz, że u Ciebie lub bliskiej osoby rozwija się błonica, koniecznie umów wizytę w poradni POZ. Lekarz dokładnie obejrzy zmiany na powierzchni błony śluzowej (nosa, gardła, krtani) i przeprowadzi wywiad medyczny. Zapyta o szczepienia pacjenta, ewentualną niedawną podróż do rejonów endemicznego występowania błonicy lub kontakt z osobą zakażoną (przy braku odporności poszczepiennej). Jeśli pojawią się wątpliwości czy źródłem zakażenia faktycznie jest maczugowiec błonicy, lekarz skieruje chorego na badania laboratoryjne.
Aby wykryć obecność maczugowców błonicy wykonuje się wymaz z gardła lub nosa. Pobraną próbkę poddaje się analizie mikroskopowej, a także prowadzi posiew, aby zidentyfikować bakterie. To pozwala ocenić, jakie leczenie antybiotykami zastosować. W niektórych przypadkach – gdy pacjent ma duszności lub inne zagrażające życiu objawy – lekarze nie czekają jednak na wyniki posiewu. Wdrażają od razu leczenie, opierając się wyłącznie na obrazie klinicznym. Przy błonicy zawsze konieczna jest hospitalizacja pacjenta, często w warunkach izolacji, aby zapobiec rozprzestrzenianiu się choroby.
Czy błonica jest uleczalna?
Obecnie właściwie leczona błonica jest uleczalna. Podstawą leczenia jest jak najszybsze podanie pacjentowi antytoksyny, w której znajdują się przeciwciała przeciwko toksynie błoniczej. Surowica neutralizuje jej toksyczne działanie, dlatego im wcześniej zostanie zastosowana, tym większa szansa na uniknięcie powikłań. Równocześnie pacjent otrzymuje antybiotyki, najczęściej penicylinę lub erytromycynę, które zwalczają samą bakterię i zmniejszają ryzyko dalszego zakażania innych osób.
Ważnymi elementami leczenia są także odpoczynek, łagodzenie objawów oraz terapia wspomagająca (tlenoterapia, kroplówki). Jeśli doszło do powikłań kardiologicznych lub neurologicznych, należy również wdrożyć wsparcie w tym zakresie. Warto wiedzieć, że w przypadku błonicy krtani konieczna jest intubacja lub nawet tracheotomia, aby ułatwić oddychanie przy zwężeniu szpary głośni.
Czy szczepienie przeciwko błonicy jest obowiązkowe?
Od lat najskuteczniejszym sposobem ochrony przed błonicą jest szczepienie ochronne. W Polsce szczepionka przeciw błonicy wpisana jest do obowiązkowego kalendarza szczepień. Podaje się ją już w pierwszym roku życia dziecka, w formie szczepionki skojarzonej (np. DTP – przeciw błonicy, tężcowi i krztuścowi). Dzieci otrzymują kilka dawek podstawowych oraz dawki przypominające w późniejszych latach.
Szczepionka jest w pełni bezpieczna – jej podanie może jednak wiązać się z wystąpieniem łagodnych odczynów miejscowych lub ogólnych. Zwykle są to: zaczerwienienie, obrzęk i ból w miejscu wkłucia, bóle głowy, stan podgorączkowy oraz uczucie rozbicia. Objawy te najczęściej ustępują po upływie doby.
Profilaktyka błonicy, czyli jak zapobiegać zakażeniu
Warto wiedzieć, że odporność na zakażenie błonicą maleje z upływem czasu, dlatego także dorośli powinni regularnie ją odnawiać. Zaleca się przyjmowanie dawki przypominającej co 10 lat – to pozwala obniżyć realne ryzyko zakażenia i wystąpienia ciężkich powikłań. Szczepienie szczególnie zaleca się:
- osobom podróżującym do krajów, gdzie błonica wciąż występuje,
- pracownikom ochrony zdrowia,
- osobom mającym kontakt z dużą liczbą dzieci.
Oprócz szczepień bardzo ważna jest także odpowiednia higiena – dokładne mycie rąk, dezynfekcja przedmiotów codziennego użytku oraz unikanie kontaktu z chorymi. Należy jednak pamiętać, że bez szczepień te środki nie są wystarczające, aby uchronić się przed zachorowaniem.
Podsumowanie
Błonica to choroba, która choć obecnie występuje w Polsce bardzo rzadko, może prowadzić do groźnych powikłań. Najlepszym sposobem na uniknięcie zakażenia oraz niebezpiecznych następstw choroby jest szczepienie ochronne. Jeśli chcesz wiedzieć więcej na ten temat, porozmawiaj z lekarzem pierwszego kontaktu w swojej poradni POZ.
Bibliografia:
- J. Walory, P. Grzesiowski, W. Hryniewicz, Stan uodpornienia mieszkańców Polski przeciwko błonicy, „Borgis – Nowa Medycyna” 1999, nr 9.
- K. Kęder, M. B. Kukulska, J. Lachota i in., Błonica – sytuacja epidemiologiczna, patogeneza, diagnostyka, metody leczenia i zapobieganie, https://www.przeglepidemiol.pzh.gov.pl/pdf-208640-127435?filename=Blonica%20_%20sytuacja.pdf (dostęp: 04.09.2025 r.).
- Serwis Ministerstwa Zdrowia i Narodowego Funduszu Zdrowia, Dlaczego szczepimy się przeciw błonicy, https://pacjent.gov.pl/aktualnosc/dlaczego-szczepimy-sie-przeciw-blonicy (dostęp: 04.09.2025 r.).